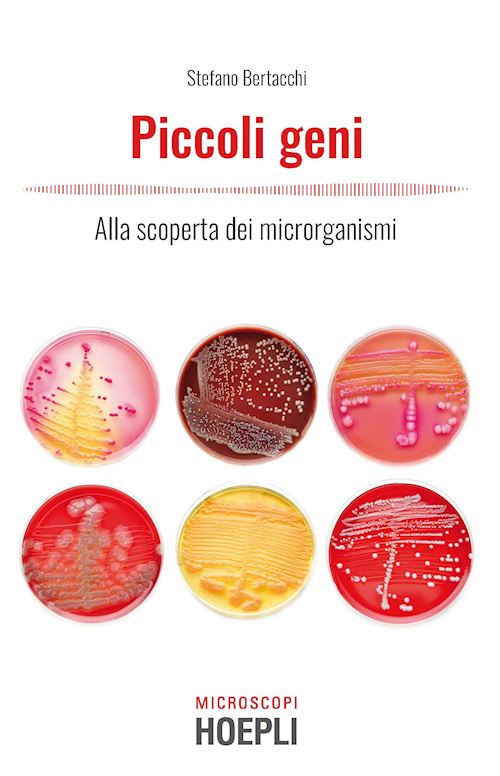

- STORIA DELLA HOEPLI HOEPLI.IT HOEPLITEST.IT CONTATTI E INFORMAZIONI SCRIVI PER NOI DOVE TROVARCI
- ARGOMENTI
- ARGOMENTI
- MATERIE LETTURE IN LINGUA PROPAGANDA SCOLASTICA HOEPLI PER LA FORMAZIONE CONTINUA DEI DOCENTI
- ARGOMENTI PROPAGANDA UNIVERSITARIA HOEPLI PER L'UNIVERSITÀ HOEPLIACADEMY+
- ARGOMENTI PROMOZIONE ITALIANO PER STRANIERI UFFICIO VENDITE ALL'ESTERO TEMI, APPROFONDIMENTI E RIFLESSIONI
- SUBJECTS FOREIGN RIGHTS DEPARTMENT INTERNATIONAL RIGHTS AGENTS